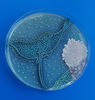

خلق آثار هنری با استفاده از میکروب و باکتری

پارسینه: در گالری امروز، توجه شما را به برندگان مسابقه «آگار آرت ۲۰۲۰» با الهام از نقش میکروبها در آثار هنری، جلب میکنیم.
آثار ارائه شده در مسابقه «آگار آرت ۲۰۲۰» با الهام از باکتریها و میکروبها خلق شده اند.

منبع:
Sputniknews
.svg)








































ارسال نظر